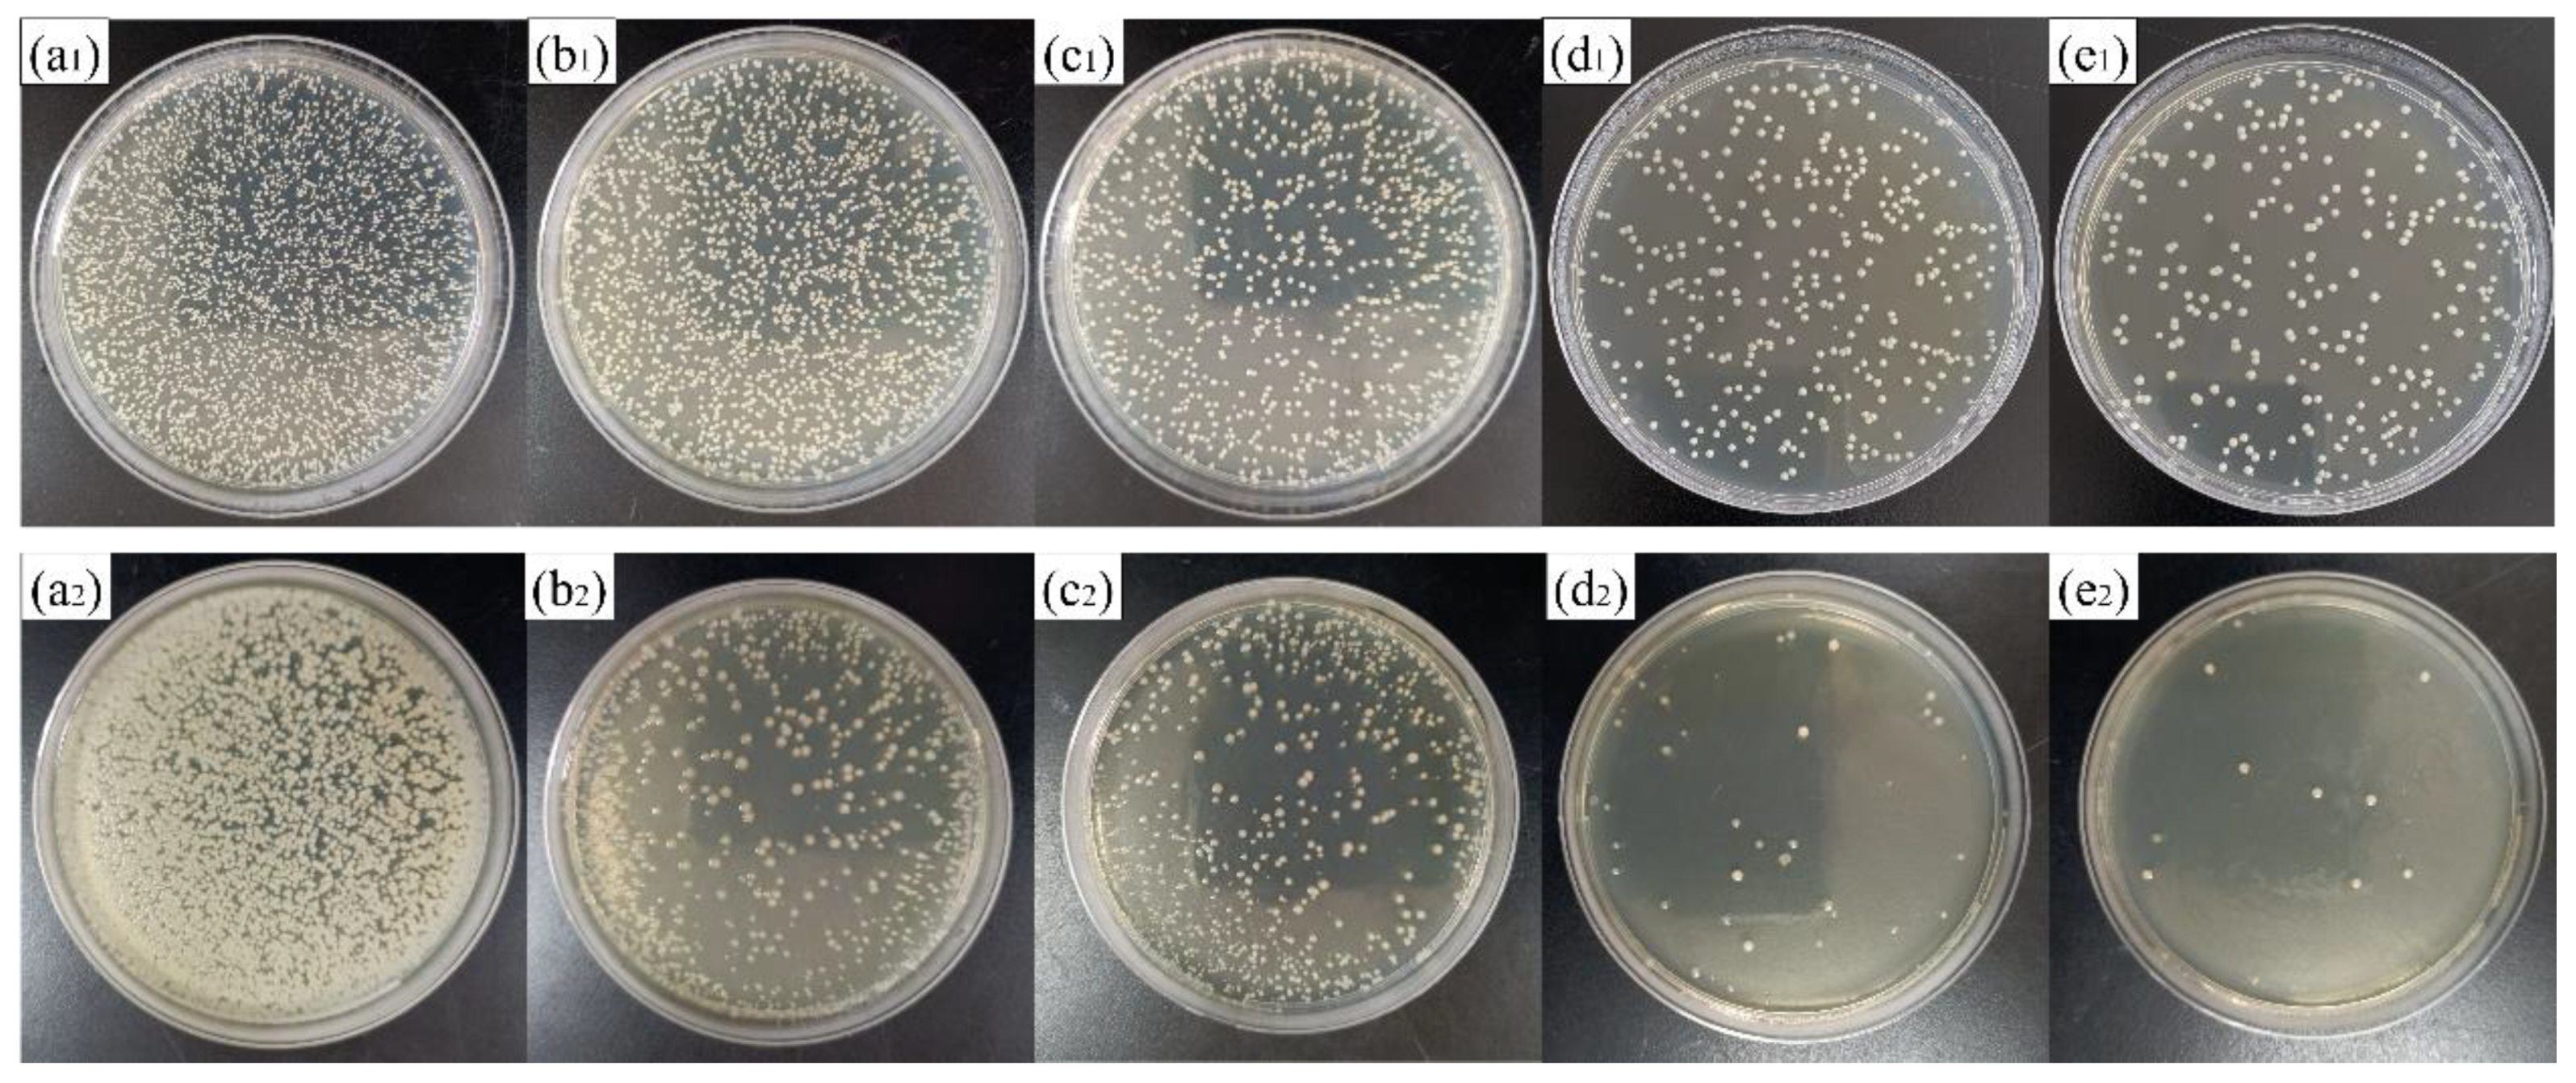
Coatings 11 00677 g010

Study on the ZrN/Ag2O Micro–Nano Gradient Composite Structure Constructed on Pure Ti for Biomaterials
Abstract
1. Introduction
2. Materials and Methods
2.1. Preparation and Modification of Specimens
2.2. Surface Characterization
2.3. Mechanical Properties Tests
2.4. Electrochemical Experiments
2.5. In Vitro Antibacterial Evaluation
2.6. Silver Ions Release
2.7. Cell Proliferation
3. Results
3.1. Coating Characterization
3.2. Mechanical Properties
3.3. Corrosion Resistance
3.4. Antimicrobial Performance and Cell Proliferation
4. Conclusions
Author Contributions
Funding
Institutional Review Board Statement
Informed Consent Statement
Data Availability Statement
Conflicts of Interest
References
- Francesca, V.; Melania, M.; Silvia, B.; Milena, F. In vivo studies on osteoinduction: A systematic review on animal models, implant site, and type and postimplantation investigation. J. Biomed. Mater. Res. Part A 2020, 108, 1834–1866. [Google Scholar]
- Ibrahim, M.Z.; Sarhan, A.A.D.; Yusuf, F.; Hamdi, M. Biomedical materials and techniques to improve the tribological, mechanical and biomedical properties of orthopedic implants—A review article. J. Alloys Compd. 2017, 714, 636–667. [Google Scholar] [CrossRef]
- O’Brien, F.J. Biomaterials & scaffolds for tissue engineering. Mater. Today 2011, 14, 88–95. [Google Scholar]
- Geetha, M.; Singh, A.K.; Asokamani, R.; Gogia, A.K. Ti based biomaterials, the ultimate choice for orthopaedic implants—A review. Prog. Mater. Sci. 2009, 54, 397–425. [Google Scholar] [CrossRef]
- Niinomi, M. Mechanical biocompatibilities of titanium alloys for biomedical applications. J. Mech. Behav. Biomed. Mater. 2008, 1, 30–42. [Google Scholar] [CrossRef]
- Bitar, D.; Parvizi, J. Biological response to prosthetic debris. World J. Orthop. 2015, 6, 172–189. [Google Scholar] [CrossRef]
- Sundfeldt, M.; Carlsson, L.V.; Johansson, C.B.; Thomsen, P.C.; Gretzer, C. Aseptic loosening, not only a question of wear: A review of different theories. Acta Orthop. 2006, 77, 177–197. [Google Scholar] [CrossRef]
- Costerton, J.W.; Stewart, P.S.; Greenberg, E.P. Bacterial biofilms: A common cause of persistent infections. Science 1999, 284, 1318–1322. [Google Scholar] [CrossRef]
- Monteiro, D.R.; Gorup, L.F.; Takamiya, A.S.; Ruvollo-Filho, A.C.; Camargo, E.R.D.; Barbosa, D.B. The growing importance of materials that prevent microbial adhesion: Antimicrobial effect of medical devices containing silver. Int. J. Antimicrob. Agents 2009, 34, 103–110. [Google Scholar] [CrossRef] [PubMed]
- Raphel, J.; Holodniy, M.; Goodman, S.B.; Heilshorn, S.C. Multifunctional coatings to simultaneously promote osteointegration and prevent infection of orthopaedic implants. Biomaterials 2016, 84, 301–314. [Google Scholar] [CrossRef]
- Delanois, R.E.; Mistry, J.B.; Gwam, C.U.; Mohamed, N.S.; Choksi, U.S.; Mont, M.A. Current epidemiology of revision total knee arthroplasty in the united states. J. Arthroplast. 2017, 32, 2663–2668. [Google Scholar] [CrossRef]
- Patel, A.; Pavlou, G.; Mujica-Mota, R.E.; Toms, A.D. The epidemiology of revision total knee and hip arthroplasty in England and Wales: A comparative analysis with projections for the United States. A study using the National Joint Registry dataset. Bone Joint J. 2015, 97, 1076–1081. [Google Scholar] [CrossRef]
- Bozic, K.J.; Kurtz, S.M.; Lau, E.; Ong, K.; Chiu, V.; Vail, T.P.; Rubash, H.E.; Berry, D.J. The epidemiology of revision total knee arthroplasty in the United States. Clin. Orthop. Relat. Res. 2010, 468, 45–51. [Google Scholar] [CrossRef]
- Fernandes, A.; Dias, M. The Microbiological profiles of infected prosthetic implants with an emphasis on the organisms which form biofilms. J. Clin. Diagn. Res. 2013, 7, 219–223. [Google Scholar] [CrossRef] [PubMed]
- Liu, X.Y.; Paul, K.C.; Ding, C.X. Surface modification of titanium, titanium alloys, and related materials for biomedical applications. Mater. Sci. Eng. R 2004, 47, 49–121. [Google Scholar] [CrossRef]
- Aranya, A.K.; Pushalkar, S.; Zhao, M.L.; Legeros, R.Z.; Zhang, Y.; Saxena, D. Antibacterial and bioactive coatings on titanium implant surfaces. J. Biomed. Mater. Res. Part A 2017, 105, 2218–2227. [Google Scholar] [CrossRef] [PubMed]
- Das, K.; Bose, S.; Bandyopadhyay, A.; Karandikar, B.; Gibbins, B.L. Surface coatings for improvement of bone cell materials and antimicrobial activities of Ti implants. J. Biomed. Mater. Res. Part B 2008, 87B, 455–460. [Google Scholar] [CrossRef]
- Kumar, D.D.; Kaliaraj, G.S. Multifunctional zirconium nitride/copper gradient coatings on medical grade 316L SS and titanium substrates for biomedical applications. J. Mech. Behav. Biomed. Mater. 2018, 77, 106–115. [Google Scholar] [CrossRef]
- Bai, W.Q.; Li, L.L.; Li, R.L.; Gu, C.D.; Wang, X.L.; Jin, G.; Liu, D.G.; Tu, J.P. Deposition and characterization of a ZrN/Zr/a-C gradient: Implication on bio-tribological and corrosion behaviors. Surf. Coat. Technol. 2017, 324, 509–517. [Google Scholar] [CrossRef]
- Rizzi, M.; Gatti, G.; Migliario, M.; Marchese, L.; Rocchetti, V.; Reno, F. Effect of zirconium nitride physical vapor deposition coating on preosteoblast cell adhesion and proliferation onto titanium screws. J. Prosthet. Dent. 2014, 112, 1103–1110. [Google Scholar] [CrossRef]
- Chernousova, S.; Epple, M. Silver as antibacterial agent: Ion, nanoparticle, and metal. Angew. Chem. Int. Ed. 2013, 52, 1636–1653. [Google Scholar] [CrossRef] [PubMed]
- Hu, G.S.; Jin, W.X.; Chen, Q.Y.; Cai, Y.C.; Zhu, Q.H.; Zhang, W.Z. Antibacterial activity of silver nanoparticles with different morphologies as well as their possible antibacterial mechanism. Appl. Phys. A Mater. Sci. Process. 2016, 122, 874. [Google Scholar] [CrossRef]
- Qin, Y.; Cheng, L.; Li, R.Y.; Liu, G.C.; Zhang, Y.B.; Tang, X.F.; Wang, J.C.; Liu, H.; Qin, Y.G. Potential antibacterial mechanism of silver nanoparticles and the optimization of orthopedic implants by advanced modification technologies. Int. J. Nanomed. 2018, 13, 3311–3327. [Google Scholar]
- Zhang, X.F.; Shen, W.; Gurunathan, S. Silver nanoparticle-mediated cellular responses in various cell lines: An in vitro model. Int. J. Mol. Sci. 2016, 17, 1603. [Google Scholar] [CrossRef] [PubMed]
- Ahamed, M.; Karns, M.; Goodson, M.; Rowe, J.; Hussain, S.M.; Schlager, J.J.; Hong, Y.L. DNA damage response to different surface chemistry of silver nanoparticles in mammalian cells. Toxicol. Appl. Pharmacol. 2008, 233, 404–410. [Google Scholar] [CrossRef]
- Xu, J.; Peng, S.; Guo, B.; Zhao, Y.T.; Fu, T.; Jiang, S.Y.; Munroe, P.; Xie, Z.H.; Lu, H. Influence of Ag alloying on the antibacterial properties, bio-corrosion resistance and biocompatibility of α-Nb5Si3 nanocrystalline coating. Appl. Surf. Sci. 2020, 503, 144082. [Google Scholar] [CrossRef]
- Ghaseminezhad, S.M.; Shojaosadati, S.A. Evaluation of the antibacterial activity of Ag/Fe3O4 nanocomposites synthesized using starch. Carbohydr. Polym. 2016, 144, 454–463. [Google Scholar] [CrossRef]
- Qin, H.; Cao, H.L.; Zhao, Y.C.; Zhu, C.; Cheng, T.; Wang, Q.J.; Peng, X.C.; Cheng, M.Q.; Wang, J.X.; Jin, G.D.; et al. In vitro and in vivo anti-biofilm effects of silver nanoparticles immobilized on titanium. Biomaterials 2014, 35, 9114–9125. [Google Scholar] [CrossRef]
- Baheiraei, N.; Moztarzadeh, F.; Hedayati, M. Preparation and Antibacterial Activity of Ag/SiO2 Thin Film on Glazed Ceramic Tiles by Sol-Gel Method. Ceram. Int. 2012, 38, 2921–2925. [Google Scholar] [CrossRef]
- Kelly, P.J.; Li, H.; Benson, P.S.; Whitehead, K.A.; Verran, J.; Arnell, R.D.; Iordanova, I. Comparison of the tribological and antimicrobial properties of CrN/Ag, ZrN/Ag, TiN/Ag, and TiN/Cu nanocomposite coatings. Surf. Coat. Technol. 2010, 205, 1606–1610. [Google Scholar] [CrossRef]
- Gao, A.; Hang, R.Q.; Huang, X.B.; Zhao, L.Z.; Zhang, X.Y.; Wang, L.; Tang, B.; Ma, S.L.; Chu, P.K. The effects of titania nanotubes with embedded silver oxide nanoparticles on bacteria and osteoblasts. Biomaterials 2014, 35, 4223–4235. [Google Scholar] [CrossRef]
- Cao, H.L.; Tang, K.W.; Liu, X.Y. Bifunctional galvanics mediated selective toxicity on titanium. Mater. Horiz. 2018, 5, 264–267. [Google Scholar] [CrossRef]
- Li, Y.; Qin, T.C.; Ingle, T.; Yan, J.; He, W.W.; Yin, J.J.; Chen, T. Differential genotoxicity mechanisms of silver nanoparticles and silver ions. Arch. Toxicol. 2017, 91, 509–519. [Google Scholar] [CrossRef] [PubMed]
- Amberg, M.; Vandenbossche, M.; Hegemann, D. Controlled Ag release from electrically conductive coating systems. Surf. Coat. Technol. 2018, 336, 29–33. [Google Scholar] [CrossRef]
- Sonia, S.; Jayram, N.D.; Kumar, P.S.; Mangalaraj, D.; Ponpandian, N.; Viswanathan, C. Effect of NaOH concentration on structural, surface and antibacterial activity of CuO nanorods synthesized by direct sonochemical method. Superlattices Microstruct. 2014, 66, 1–9. [Google Scholar] [CrossRef]
- Liu, Y.; Zheng, Z.; Zara, J.N.; Hsu, C.; Soofer, D.E.; Lee, K.S.; Siu, R.K.; Miller, L.S.; Zhang, X.; Carpenter, D.; et al. The antimicrobial and osteoinductive properties of silver nanoparticle/poly (DL-lactic-co-glycolic acid)-coated stainless steel. Biomaterials 2012, 33, 8745–8756. [Google Scholar] [CrossRef]
- Li, J.H.; Qiao, Y.Q.; Zhu, H.Q.; Meng, F.H.; Liu, X.Y. Existence, release, and antibacterial actions of silver nanoparticles on Ag–PIII TiO2 films with different nanotopographies. Int. J. Nanomed. 2014, 9, 3389–3402. [Google Scholar] [CrossRef] [PubMed]
- Ma, M.; Wan, R.X.; Gong, H.H.; Lv, X.F.; Chu, S.S.; Li, D.J.; Gu, H.Q.; Peng, C. Study on the in vitro and in vivo antibacterial activity and biocompatibility of novel TiN/Ag gradients immobilized onto biomedical titanium. J. Nanosci. Nanotechnol. 2019, 19, 3777–3791. [Google Scholar] [CrossRef]
- Lei, Z.F.; Zhang, Q.Q.; Zhu, X.D.; Ma, D.Y.; Ma, F.; Song, Z.X.; Fu, Y.Q. Corrosion performance of ZrN/ZrO2 gradient coatings deposited on 304 stainless steel using multi-arc ion plating. Appl. Surf. Sci. 2018, 431, 170–176. [Google Scholar] [CrossRef]
- Herbster, M.; Doring, J.; Nohava, J.; Lohmann, C.H.; Halle, T.; Bertrand, J. Retrieval study of commercially available knee implant coatings TiN, TiNbN and ZrN on TiAl6V4 and CoCr28Mo6. J. Mech. Behav. Biomed. Mater. 2020, 112, 104034. [Google Scholar] [CrossRef]
- Xu, J.; Sun, T.T.; Jiang, S.Y.; Munroe, P.; Xie, Z.H. Antimicrobial and biocorrosion-resistant MoO3-SiO2 nanocomposite coating prepared by double cathode glow discharge technique. Appl. Surf. Sci. 2018, 447, 500–511. [Google Scholar] [CrossRef]

| Specimens | Ecorr (V) | icorr (nA/cm2) | Corrosion Rate (10−6 mm/year) |
|---|---|---|---|
| Ti-Sub | −0.266 | 73.6 | 638 |
| ZrN coating | −0.215 | 53.7 | 466 |
| ZrN/Ag2O (1 × 1016) | −0.092 | 35.5 | 308 |
| ZrN/Ag2O (5 × 1016) | −0.086 | 31.8 | 276 |
| ZrN/Ag2O (10 × 1016) | −0.098 | 31.7 | 275 |
| ZrN/Ag2O (15 × 1016) | −0.050 | 29.5 | 256 |
| Specimens | Rs (Ω·cm−2) | Rct (Ω·cm−2) | Qdl (μF·cm−2) | Qdl-n | Rb (Ω·cm−2) | Qb (μF·cm−2) | Qb-n |
|---|---|---|---|---|---|---|---|
| Ti-Sub | 22.1 | 35.9 | 72.0 | 0.898 | 1.83 × 106 | 8.29 | 0.974 |
| ZrN coating | 24.6 | 254 | 40.3 | 0.850 | 4.65 × 106 | 11.8 | 0.846 |
| ZrN/Ag2O (1 × 1016) | 22.2 | 20.9 | 25.5 | 0.872 | 3.98 × 106 | 11.1 | 0.947 |
| ZrN/Ag2O (5 × 1016) | 23.0 | 31.3 | 30.2 | 0.859 | 4.91 × 106 | 10.4 | 0.973 |
| ZrN/Ag2O (10 × 1016) | 25.5 | 84.9 | 28.8 | 0.844 | 10.30 × 106 | 10.3 | 0.982 |
| ZrN/Ag2O (15 × 1016) | 25.0 | 58.7 | 36.5 | 0.859 | 8.26 × 106 | 7.01 | 0.985 |
| Specimens | 24 h (OD) | Grade | 3 d (OD) | Grade |
|---|---|---|---|---|
| Ti-Sub | 0.744 | - | 1.323 | - |
| ZrN/Ag2O (1 × 1016) | 0.801 | 0 | 1.207 | 1 |
| ZrN/Ag2O (5 × 1016) | 0.425 | 2 | 1.316 | 1 |
| ZrN/Ag2O (10 × 1016) | 0.532 | 2 | 1.144 | 1 |
| ZrN/Ag2O (15 × 1016) | 0.403 | 2 | 1.560 | 0 |
Publisher’s Note: MDPI stays neutral with regard to jurisdictional claims in published maps and institutional affiliations. |
© 2021 by the authors. Licensee MDPI, Basel, Switzerland. This article is an open access article distributed under the terms and conditions of the Creative Commons Attribution (CC BY) license (https://creativecommons.org/licenses/by/4.0/).
Share and Cite
Tian, T.; Dang, B.; Ding, F.; Li, F.; Yang, K.; Yuan, J.; Wei, D.; Zhang, P. Study on the ZrN/Ag2O Micro–Nano Gradient Composite Structure Constructed on Pure Ti for Biomaterials. Coatings 2021, 11, 677. https://doi.org/10.3390/coatings11060677
Tian T, Dang B, Ding F, Li F, Yang K, Yuan J, Wei D, Zhang P. Study on the ZrN/Ag2O Micro–Nano Gradient Composite Structure Constructed on Pure Ti for Biomaterials. Coatings. 2021; 11(6):677. https://doi.org/10.3390/coatings11060677
Chicago/Turabian StyleTian, Tian, Bo Dang, Feng Ding, Fengkun Li, Kai Yang, Jianzhi Yuan, Dongbo Wei, and Pingze Zhang. 2021. "Study on the ZrN/Ag2O Micro–Nano Gradient Composite Structure Constructed on Pure Ti for Biomaterials" Coatings 11, no. 6: 677. https://doi.org/10.3390/coatings11060677
APA StyleTian, T., Dang, B., Ding, F., Li, F., Yang, K., Yuan, J., Wei, D., & Zhang, P. (2021). Study on the ZrN/Ag2O Micro–Nano Gradient Composite Structure Constructed on Pure Ti for Biomaterials. Coatings, 11(6), 677. https://doi.org/10.3390/coatings11060677

